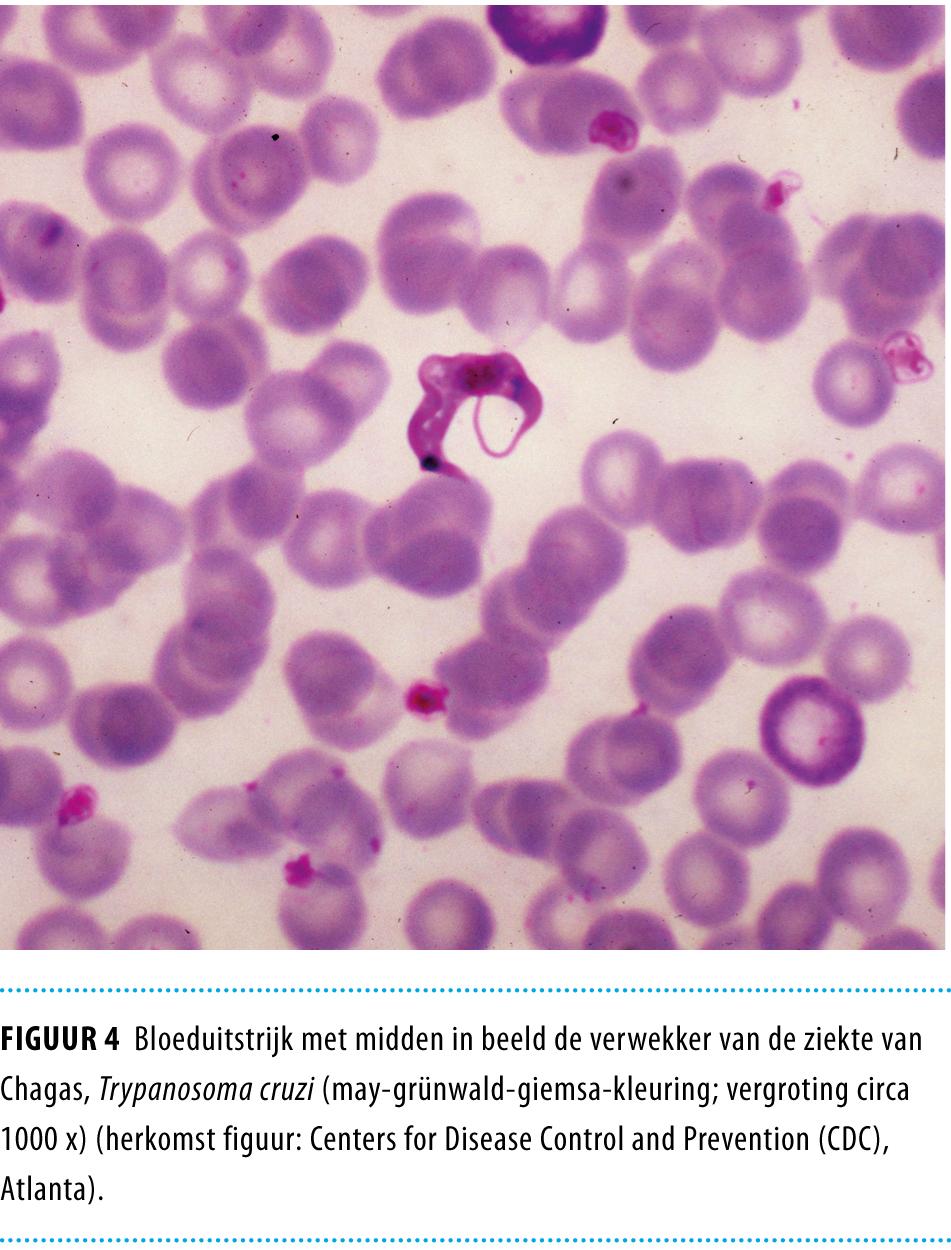
Figuur 5

Toets voor nascholing (verlopen)
Aan dit artikel was een toets gekoppeld waarmee je nascholingspunten kon verdienen.
Samenvatting
-
Wereldwijd zijn 8-10 miljoen personen, voornamelijk bewoners van Latijns-Amerika, geïnfecteerd met Trypanosoma cruzi, de parasiet die de ziekte van Chagas veroorzaakt.
-
Door toegenomen migratie is de ziekte van Chagas buiten Latijns-Amerika sterk toegenomen, ook in Europa.
-
De ziekte van Chagas, ook Amerikaanse trypanosomiasis genoemd, verloopt in 2 fases, een acute fase die circa 2 maanden duurt en een chronische fase waarin symptomen jaren na de besmetting kunnen optreden. Zonder behandeling blijft de patiënt levenslang geïnfecteerd.
-
De acute fase verloopt doorgaans asymptomatisch; in de chronische fase van Amerikaanse trypanosomiasis kunnen ernstige gastro-intestinale en cardiale afwijkingen ontstaan, met uiteindelijk een dodelijke afloop.
-
In Nederland zijn naar schatting tussen de 726 en 2929 immigranten seropositief voor Amerikaanse trypanosomiasis.
-
Zorgverleners kunnen steeds vaker met patiënten met de ziekte van Chagas geconfronteerd worden.
-
Screening van zwangeren en bloeddonoren uit risicogroepen op Amerikaanse trypanosomiasis zou overwogen moeten worden.
artikel
De ziekte van Chagas, of Amerikaanse trypanosomiasis, wordt veroorzaakt door infectie met de eencellige parasiet Trypanosoma cruzi, die endemisch voorkomt in delen van Midden- en Zuid-Amerika. Wereldwijd zijn naar schatting 8-10 miljoen mensen besmet.1 Tot een decennium geleden was de ziekte van Chagas een zeldzame importziekte in Europa. Door een sterke toename van de Latijns-Amerikaanse migrantenstroom naar Europa is dit veranderd.
Door screeningsonderzoek onder bloeddonoren en zwangeren zijn in Spanje meer dan 3500 (import)infecties serologisch bewezen. Recente schattingen van het totaal aantal personen in Spanje dat seropositief is voor Amerikaanse trypanosomiasis lopen uiteen van 40.000 tot 65.000.2 Uit actief opsporingsonderzoek in Zwitserland bleek een seroprevalentie van 12,8% onder illegale Latijns-Amerikaanse immigranten.3 In dit artikel geven wij een kort overzicht van de mogelijke ontwikkelingen aangaande Amerikaanse trypanosomiasis in Nederland in de nabije toekomst.
Cyclus en klinisch beeld
In endemische gebieden vindt transmissie vooral plaats via een beet door een geïnfecteerde bloedzuigende wants, de ‘kissing bug’ (figuur 1a). Deze wijze van overdracht komt vooral voor in arme landelijke gebieden waar mensen leven in eenvoudige behuizing met schuilplaatsen voor in huis levende wantsen. De bijnaam ‘kissing bug’ refereert aan het bijten van de wants in het gelaat van de gastheer; de wants wordt namelijk aangetrokken door onder andere uitgeademd kooldioxide.

Cyclus
De geïnfecteerde wants is de vector. Deze deponeert tijdens een bloedmaal besmette feces nabij het beetwondje. De trypanosomen kunnen vervolgens binnendringen wanneer de gastheer over de jeukende beetwond wrijft of krabt, of via conjunctiva of mucosa. Verschillende gedomesticeerde dieren, zoals honden en katten, maar ook wilde zoogdieren als gordeldieren en knaagdieren, kunnen besmet worden en dienen als reservoir. Lokale uitbraken door orale besmetting via besmet voedsel zijn zeldzaam. Transmissie kan ook plaatsvinden door bloedtransfusie, orgaantransplantatie of tijdens de zwangerschap van moeder op kind.
In Latijns-Amerika wordt de ziekte van Chagas bestreden door een combinatie van vectorcontrole op het platteland en verplichte screening onder zwangeren en in bloedbanken. In grote internationale programma’s hebben deze maatregelen geleid tot een sterke reductie van de ziekte van Chagas in meerdere Latijns-Amerikaanse landen.4
Er zijn 2 fases in de ziekte van Chagas. De acute fase, die ongeveer 2 maanden duurt en al dan niet met symptomen gepaard gaat, wordt gevolgd door de chronische fase, waarin eventuele symptomen pas jaren na de besmetting kunnen optreden.
Klinisch beeld
Doorgaans verloopt de acute fase zonder klinische verschijnselen. Bij symptomatische patiënten, meestal kinderen, kan na een incubatietijd van 7-10 dagen een lokale ontstekingsreactie rond het beetwondje ontstaan, bekend als het ‘chagoom’. Bij infectie via de conjunctiva kan een typisch beeld van eenzijdig periorbitaal oedeem met zwelling van het ooglid optreden; dit staat bekend als het teken van Romaña (‘Romaña’s sign’) (figuur 1b). Vervolgens kan een mild verlopende ziekte optreden, met weinig specifieke symptomen als koorts, malaise, lymfadenopathie en hepatosplenomegalie. Zelden treedt acute myocarditis of meningo-encefalitis op.1,5 Bij transmissie door bloedtransfusie is de incubatietijd doorgaans langer, 20-40 dagen, en ontbreken uiteraard chagoom of het teken van Romaña.
Wanneer patiënten niet behandeld worden, blijven zij levenslang geïnfecteerd. De parasieten infecteren onder meer de spiercellen en zenuwcellen van het hart en de tractus digestivus. De cellulaire afweerreactie beperkt de vermenigvuldiging van de parasiet, maar kan deze niet klaren.
Van de chronisch geïnfecteerde patiënten ontwikkelt 20-30% klinisch manifeste cardiomyopathie (figuur 2).1 Deze begint meestal met geleidingsstoornissen, die zichtbaar zijn op het ECG.7 De belangrijkste doodsoorzaken bij patiënten die overlijden ten gevolge van deze infectie zijn plotselinge dood door ventriculaire ritmestoornissen of een compleet hartblok (50%), overlijden aan de gevolgen van hartfalen (37%) of embolieën.8,9

Bij 10-15% van de chronisch geïnfecteerden treden gastro-intestinale afwijkingen op.1 Door progressieve schade aan autonome zenuwcellen kunnen motiliteitsstoornissen en uiteindelijk mega-oesofagus en megacolon ontstaan (figuur 3).10 De slokdarmafwijkingen bij de ziekte van Chagas onderscheiden zich niet van die bij idiopathische achalasie. Ook de colonafwijkingen bij de ziekte van Chagas zijn niet specifiek.

Bij chronisch geïnfecteerde patiënten die immuungecompromitteerd raken, kan reactivatie plaatsvinden. Deze gaat vaak met myocarditis of meningo-encefalitis gepaard.
Epidemiologie in Nederland
De ziekte van Chagas is in Nederland incidenteel gerapporteerd bij Latijns-Amerikaanse immigranten, dus als importziekte.2,11 Het aantal Latijns-Amerikanen in Nederland is het laatste decennium sterk toegenomen. Een soortgelijke toename leidde elders in Europa tot een sterke toename van het aantal personen dat seropositef was voor T. cruzi.2,3 In Nederland ontbreken precieze cijfers, omdat geen actieve opsporing plaatsvindt, noch screening door bloedbanken.
Voor een schatting van het aantal seropositieven kan men het aantal immigranten vermenigvuldigen met de prevalentie in het land van herkomst.12-14 Als we deze schatting uitvoeren voor Nederland, op basis van bevolkingsgegevens van het CBS in combinatie met seroprevalentiecijfers volgens de pan-Amerikaanse gezondheidsorganisatie (PAHO),4 zouden er momenteel 2929 geïnfecteerde Latijns-Amerikanen in Nederland zijn, van wie 2388 uit Suriname (tabel). Illegale Latijns-Amerikanen en in Nederland geboren personen die seropositief waren voor T. cruzi werden in deze schatting buiten beschouwing gelaten.

Prevalentie in Suriname: 2 schattingen
De geschatte prevalentie van de ziekte van Chagas in Nederland wordt sterk bepaald door de prevalentie in Suriname. Recent onderzoek suggereert dat de seroprevalentie in Suriname mogelijk lager is dan de aanname van de PAHO, die 1,29% bedraagt. Het is niet geheel duidelijk op welke data de PAHO-schattingen precies gebaseerd zijn.
Voor zover wij weten is er slechts 1 studie naar seroprevalentie in Suriname gepubliceerd. Volgens deze studie waren 2 van 200 marrons (bewoners van het binnenland) seropositief voor Amerikaanse trypanosomiasis; dit is een prevalentie van 1%.15 In dezelfde studie waren 500 bloeddonoren en 100 hartpatiënten seronegatief. De seropositieve marrons waren afkomstig uit het midden van het land. Verder is de infectie aangetoond bij 1 patiënt woonachtig in de kustvlakte van Suriname.16
In Frans Guyana, in plaatsen langs de Marowijne-rivier grenzend aan oostelijk Suriname, werd in een recente, grote studie een seroprevalentie van 0,7% (6/864) gevonden.17 Omgevingsfactoren en leefomstandigheden voor de bewoners zijn voor beide landen in dit gebied vrijwel gelijk en er is veel verkeer over de rivier. Ook de wantssoorten die de ziekte van Chagas kunnen overbrengen en de buidelrat en het gordeldier, belangrijke dierlijke reservoirs van T. cruzi, komen in het binnenland van Suriname frequent voor (Hélène Hiwat, schriftelijke mededeling, 2011).
Als wij 0,7% hanteren als beste schatting voor de prevalentie van Amerikaanse trypanosomiasis in het binnenland van Suriname, en die in de kuststreek op 0% stellen, komt de prevalentie voor de hele Surinaamse bevolking op 0,1%. De aanname dat de kuststreek vrij is van de ziekte van Chagas, is overigens geen vaststaand feit, al is de infectie daar waarschijnlijk zeldzaam (S.M. Burke-Hermelijn en D. Panchoe, schriftelijke mededeling, 2011). Als de lagere schatting van de prevalentie gehanteerd wordt, zou het aantal Surinamers in Nederland dat geïnfecteerd is met T. cruzi uitkomen op 185. In totaal zouden er dan 726 seropositieven in Nederland zijn (zie de tabel).
Diagnostiek
Tijdens de acute fase zijn de parasieten vaak microscopisch te detecteren in een dikkedruppelpreparaat, een bloeduitstrijkje (figuur 4), de microhematocriet-centrifugatiemethode of kwantitatieve analyse van de buffy coat (QBC). De microhematocrietmethode berust op concentratie van de parasieten in de buffy coat. Hierbij wordt zonder kleurstof onder een normale microscoop direct naar bewegende parasieten gekeken. Bij de QBC-methode worden de parasieten aangekleurd met acridine-oranje, waarna zij onder een fluorescentiemicroscoop zichtbaar zijn.
Tijdens de chronische fase is de parasitemie echter zo laag, dat deze nauwelijks met microscopische methoden aan te tonen is. In gebieden waar de ziekte endemisch is, wordt daarom de xenodiagnose gebruikt. Bij die methode laat men ongeïnfecteerde wantsen zich voeden met bloed van de patiënt. Na enkele weken worden de uitwerpselen van de wantsen microscopisch onderzocht op de parasiet.
In Nederland, waar de xenodiagnose niet operationeel is, berust diagnostiek in de chronische fase op het aantonen van antistoffen tegen de trypanosomen middels serologisch onderzoek. Voorheen werd dit onderzoek uitsluitend in België verricht, recent ook in het Academisch Medisch Centrum (AMC) te Amsterdam. Geen enkele serologische test heeft echter voldoende hoge sensitiviteit en specificiteit om de diagnose op basis van één test met zekerheid te kunnen stellen. Daarom adviseert de WHO om een positieve test te bevestigen met een tweede serologische test, met een andere techniek of met een serologische test gericht op andere antigenen.18 Op de onderafdeling Parasitologie van het AMC gebruikt men een combinatie van dipstick, ELISA en Western blot.
Behandeling en beleid
Benznidazol en nifurtimox zijn de enige middelen met bewezen werkzaamheid tegen Amerikaanse trypanosomiasis. Geen van beide geneesmiddelen is in Nederland geregistreerd; nifurtimox is verkrijgbaar via de WHO, benznidazol via de Braziliaanse overheid.
Bij maximaal 80% van de patiënten die zijn behandeld voor een recente infectie is de parasiet na de behandeling niet meer aantoonbaar.19 In het afgelopen decennium is de betekenis van een aanhoudende infectie met T. cruzi voor de chronische vorm van de ziekte van Chagas onderkend. Er wordt in toenemende mate voor gekozen om ook asymptomatische patiënten met trypanosomiasis te behandelen met antiparasitaire middelen.19,20 Bij asymptomatische kinderen had dit tot nog toe het meeste succes: na 3-4 jaar vertoonde 60% een conversie van een positieve naar een negatieve reactie bij serologische tests.19 Door gebrek aan studies en heterogeniteit van populaties, behandelschema’s, uitkomstmaten en follow-up bestaat slechts beperkt bewijs dat deze behandeling ook bij langer geïnfecteerde volwassenen de kans op complicaties verkleint.21,22
Sinds 2004 is een groot multicentrisch onderzoek gaande naar de effecten van deze behandeling bij volwassenen, de zogenoemde BENEFIT-trial; de resultaten hiervan worden spoedig verwacht.23 Recente reviews uit Latijns-Amerika, de VS en Europa raden aan om alle geïnfecteerden onder 18 jaar en alle patiënten met acute trypanosomiasis te behandelen, en behandeling aan te bieden aan alle asymptomatische patiënten van 19-50 jaar.1,5,20
Controle op complicaties
Asymptomatische patiënten moeten periodiek gecontroleerd worden op tekenen van cardiomyopathie, zodat tijdig de juiste symptomatische behandeling kan worden geboden. In de VS en Latijns-Amerika is het beleid om anamnese, lichamelijk onderzoek en ecg te verrichten. Als het ecg geen afwijkingen vertoont, wordt het onderzoek jaarlijks herhaald.5 Verwijzing naar de cardioloog is geïndiceerd als er anamnestisch aanwijzingen zijn voor hartafwijkingen (hartkloppingen, wegrakingen, pijn op de borst of tekenen van hartfalen of embolieën) of als het ecg afwijkend is (ritme- of geleidingsstoornissen, pathologische Q-top of laag QRS-voltage). Specifiek gastro-enterologisch vervolgonderzoek zou in eerste instantie kunnen bestaan uit het vragen naar de symptomen dysfagie en obstipatie. In de volgende stap zou beeldvormend onderzoek van slokdarm of colon kunnen volgen.
Beschouwing
In Europa is de ziekte van Chagas in het laatste decennium een belangrijke importinfectie geworden, met in enkele landen zelfs verticale en transfusiegerelateerde verspreiding. De WHO heeft dan ook initiatieven ontplooid om het vóórkomen van de ziekte van Chagas in Europa in kaart te brengen en eventuele acties verder te coördineren.2 Ook in Nederland kunnen zorgverleners met patiënten met T. cruzi-infectie te maken krijgen, onder meer huisartsen, cardiologen, gastro-enterologen, kinderartsen en zorgverleners in de verloskundige zorg en de bloedtransfusiedienst.
Het is aan te bevelen om de ziekte van Chagas in de differentiaaldiagnose op te nemen bij patiënten met klachten passend bij cardiomyopathie, achalasie of ernstige obstipatie met megacolon die langdurig verbleven in Latijns-Amerika, een Latijns-Amerikaanse moeder hebben of een bloedtransfusie hebben ondergaan in Latijns-Amerika; wij adviseren bij deze patiënten specifieke diagnostiek te laten verrichten. Wanneer een serologisch positieve vrouw wordt geïdentificeerd, is screening van haar kinderen aangewezen. Ook is screening geïndiceerd bij familie en vrienden van serologisch positieve personen die vergelijkbare risico’s op blootstelling hebben gelopen.5
De werkelijke prevalentie kan hoger, maar ook lager uitvallen dan de hier gepresenteerde schattingen. Alleen door gericht serologisch onderzoek in risicogroepen kan de juistheid van de prevalentieschattingen bepaald worden. Momenteel wordt door de bloedbank in Suriname onderzoek verricht naar de aanwezigheid van antistoffen bij bloeddonoren. Vanwege het risico op transmissie van de ziekte van Chagas wordt in buurland Frans Guyana al het benodigde donorbloed uit Frankrijk geïmporteerd.
Gerichte studie in risicogroepen in Nederland lijkt gerechtvaardigd, gezien de potentiële ernst van de ziekte en de mogelijkheid tot behandeling. Gezien het hoge percentage vrouwen in de vruchtbare leeftijd onder Latijns-Amerikaanse immigranten, en de duidelijke voordelen van behandeling bij geïnfecteerde neonaten, komt deze groep hier met name voor in aanmerking. Ook in andere Europese landen is gekozen voor deze benadering.2
Eventueel serologisch onderzoek onder risicogroepen vereist naast gedegen voorlichting ook een duidelijk klinisch beleid bij personen die seropositief blijken te zijn. Hiertoe is een zorgvuldige multidisciplinaire follow-up in een gespecialiseerd centrum aan te bevelen, met name gezien de moeilijkheden bij laboratoriumdiagnostiek en klinische diagnostiek en het stellen van een goede indicatie voor behandeling.
Leerpunten
-
Trypanosoma cruzi, de parasiet die de ziekte van Chagas veroorzaakt, kan worden overgedragen door wantsen en besmet voedsel in Latijns-Amerika en via bloedtransfusies, orgaantransplantaties en congenitale besmetting.
-
Door toegenomen migratie is de ziekte van Chagas buiten Latijns-Amerika sterk toegenomen.
-
Geschat wordt dat er tussen de 726 en 2929 immigranten in Nederland seropositief zijn voor T. cruzi.
-
20-40% van de chronisch geïnfecteerde personen ontwikkelt jaren na de besmetting gastro-intestinale of cardiale afwijkingen.
-
Zorgverleners dienen alert te zijn op de ziekte van Chagas; risicofactoren zijn onder meer langdurig verblijf in Latijns-Amerika en het hebben ondergaan van een bloedtransfusie in een Latijns-Amerikaans land.
Literatuur
-
Rassi A Jr, Rassi A, Marin-Neto JA. Chagas disease. Lancet. 2010;375:1388-402 Medline. doi:10.1016/S0140-6736(10)60061-X
-
World Health Organization. Control and prevention of Chagas disease in Europe. Genève: WHO; 2010.link
-
Jackson Y, Getaz L, Wolff H, et al. Prevalence, clinical staging and risk for blood-borne transmission of Chagas disease among Latin American migrants in Geneva, Switzerland. PLoS Negl Trop Dis. 2010;4:e592 Medline. doi:10.1371/journal.pntd.0000592
-
Organización Panamericana de la Salud. Estimación cuantitativa de la enfermedad de Chagas en las Américas. Montevideo, Uruguay: Organización Panamericana de la Salud OPS/HDM/CD/425-06; 2006.
-
Bern C, Montgomery SP, Herwaldt BL, et al. Evaluation and treatment of chagas disease in the United States: a systematic review. JAMA. 2007;298:2171-81 Medline. doi:10.1001/jama.298.18.2171
-
Martínez S, Restrepo CS, Carrillo JA, et al. Thoracic Manifestations of Tropical Parasitic Infections: A Pictorial Review. RadioGraphics. 2005;25:135-55 Medline.
-
Maguire JH, Hoff R, Sherlock I, et al. Cardiac morbidity and mortality due to Chagas’ disease: prospective electrocardiographic study of a Brazilian community. Circulation. 1987;75:1140-5 Medline.
-
Rassi A Jr, Rassi A, Little WC, et al. Development and validation of a risk score for predicting death in Chagas’ heart disease. N Engl J Med. 2006;355:799-808 Medline. doi:10.1056/NEJMoa053241
-
Yacoub S, Mocumbi AO, Yacoub MH. Neglected tropical cardiomyopathies: I. Chagas disease: myocardial disease. Heart. 2008;94:244-8 Medline. doi:10.1136/hrt.2007.132316
-
de Oliveira RB, Troncon LE, Dantas RO, Menghelli UG. Gastrointestinal manifestations of Chagas’ disease. Am J Gastroenterol. 1998;93:884-9 Medline. doi:10.1016/S0002-9270(98)00151-8
-
Marcu CB, Beek AM, Van Rossum AC. Chagas’ heart disease diagnosed on MRI: the importance of patient ‘geographic’ history. Int J Cardiol. 2007;117:e58-60 Medline. doi:10.1016/j.ijcard.2006.11.114
-
Schmunis GA, Yadon ZE. Chagas disease: a Latin American health problem becoming a world health problem. Acta Trop. 2010;115:14-21 Medline. doi:10.1016/j.actatropica.2009.11.003
-
Gascon J, Bern C, Pinazo MJ. Chagas disease in Spain, the United States and other non-endemic countries. Acta Trop. 2010;115:22-7 Medline. doi:10.1016/j.actatropica.2009.07.019
-
Guerri-Guttenberg RA, Grana DR, Ambrosio G, Milei J. Chagas cardiomyopathy: Europe is not spared! Eur Heart J. 2008;29:2587-91 Medline. doi:10.1093/eurheartj/ehn424
-
Rawlins SC, Baboolal S, Parsad K, et al. The prevalence of antibodies to Trypanosoma cruzi in Guyana, Suriname and Trinidad & Tobago. Surinam Medical Bulletin. 2001;16:25-40.
-
Oostburg BF, Anijs JE, Oehlers GP, Hiwat HO, Burke-Hermelijn SM. Case report: the first parasitologically confirmed autochthonous case of acute Chagas disease in Suriname. Trans R Soc Trop Med Hyg. 2003;97:166-7 Medline. doi:10.1016/S0035-9203(03)90108-8
-
Aznar C, La RG, Laventure S, Carme B, Liegeard P, Hontebeyrie M. Seroprevalence of Trypanosoma cruzi infection in French Guiana. Mem Inst Oswaldo Cruz. 2004;99:805-8 Medline. doi:10.1590/S0074-02762004000800004
-
WHO Expert Committee on the Control of Chagas Disease. Control of Chagas disease: second report of the WHO expert committee. WHO technical report series, nr. 905. Genève: WHO; 2002.link
-
Urbina JA. Specific chemotherapy of Chagas disease: relevance, current limitations and new approaches. Acta Trop. 2010;115:55-68 Medline. doi:10.1016/j.actatropica.2009.10.023
-
Lescure FX, Le LG, Freilij H, et al. Chagas disease: changes in knowledge and management. Lancet Infect Dis. 2010;10:556-570 Medline. doi:10.1016/S1473-3099(10)70098-0
-
Pérez-Molina JA, Perez-Ayala A, Moreno S, Fernandez-Gonzalez MC, Zamora J, Lopez-Velez R. Use of benznidazole to treat chronic Chagas’ disease: a systematic review with a meta-analysis. J Antimicrob Chemother. 2009;64:1139-47 Medline. doi:10.1093/jac/dkp357
-
Villar JC, Marin-Neto JA, Ebrahim S, Yusuf S. Trypanocidal drugs for chronic asymptomatic Trypanosoma cruzi infection. Cochrane Database Syst Rev. 2002;CD003463 Medline.
-
Marin-Neto JA, Rassi A Jr, Morillo CA, et al. Rationale and design of a randomized placebo-controlled trial assessing the effects of etiologic treatment in Chagas’ cardiomyopathy: the BENznidazole Evaluation For Interrupting Trypanosomiasis (BENEFIT). Am Heart J. 2008;156:37-43 Medline. doi:10.1016/j.ahj.2008.04.001





Reacties